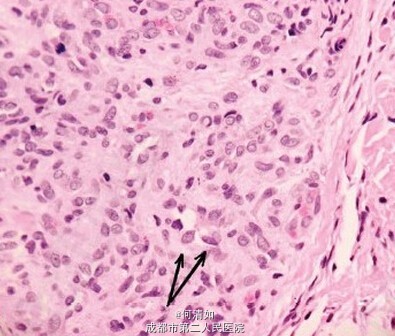

下载或打开 医联APP 查看完整评论
立即下载
打开APP
霰粒肿?
主诉 病史
女,27岁,右下眼睑肿胀3周。 无外伤史,无系统性疾病。 初诊:霰粒肿

查体 辅查
眼科常规检查无异常。 拟局麻下清除病灶,术中组织表现为肉质、红色、出血性、质地坚韧。 考虑到与霰粒肿表现不一,术中全部切除病灶,并行组织病理学检查。 血常规、尿常规、肝肾功能检查、胸片、腹部超声均在正常范围内。

诊断 处理
诊断:上皮样血管内皮瘤 处理:全切
随访 讨论
经2年以上随访,无局部复发或远处转移。 上皮样血管内皮瘤是一种罕见的血管瘤,被认为是在上皮样血管瘤(良性)和上皮样血管肉瘤(高度恶性)中间。它可以影响许多器官如肝、骨、肺、皮肤、软组织,而眼睑累及是极为罕见的。 因为眼睑上皮样血管内皮瘤是一种低度恶性病变,其复发率高(没有完全切除活检),但很少转移。此例患者病损完整切除,不需要其他局部切除术治疗。此外,辅助放疗或化疗疗效有待进一步证明。 临床表现类似霰粒肿,易误诊。
发布于 15-05-31 09:45
